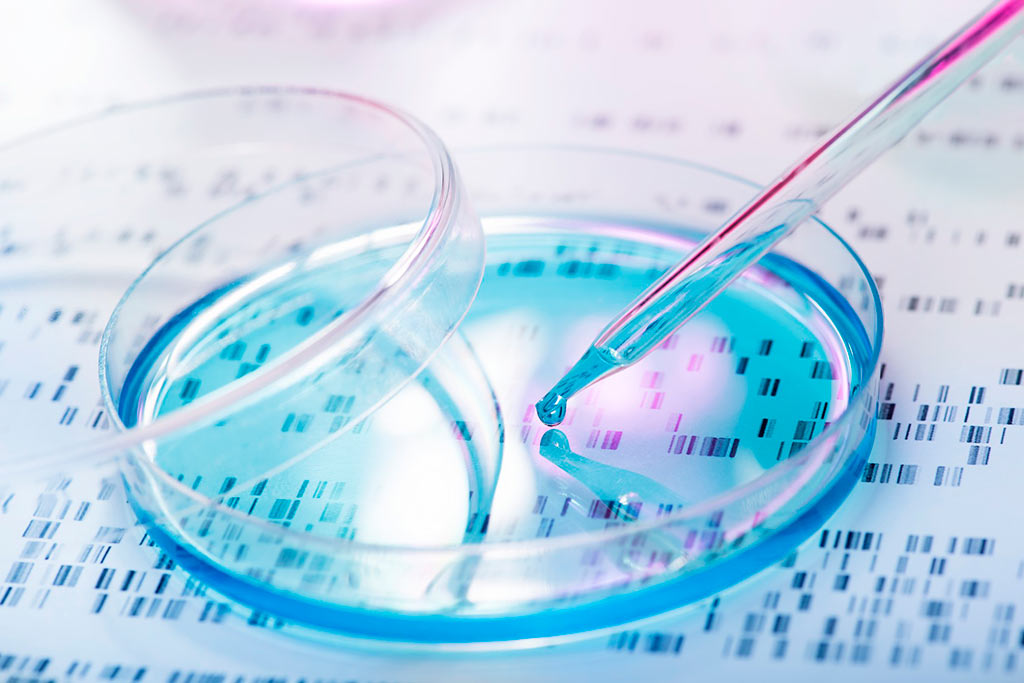

Матрица для лечения суставов
Патология поражает преимущественно лиц пожилого возраста. По статистике, артроз выявляют у 80% людей старше 75 лет. Чаще выявляют у мужчин и женщин моложе 45 лет. Такое положение вещей вынуждает ученых искать альтернативные методы лечения ОА, позволяющие побороть его без травматичного хирургического вмешательства.

Здоровая хрящевая ткань в сравнении с дегенеративно измененной головкой бедренной кости.
Для остеоартроза характерно поражение крупных суставов, сопровождающееся разрушением внутрисуставных хрящей. Из-за нарушения кровоснабжения и обмена веществ хрящевая ткань отекает и теряет эластичность, что приводит к развитию деструктивных процессов. Со временем хрящи изнашиваются и истончаются. В дальнейшем генеративные процессы распространяются на эпифизы костей, участвующих в формировании сустава.

Так выглядит хрящ коленного сустава при остеоартрозе.
В настоящее время ученые из разных стран проводят исследования, главная цель которых – научиться восстанавливать нормальную структуру суставных хрящей. К сожалению, им еще не удалось разработать универсального метода, позволяющего победить ОА без операции.
Факт! На сегодня эндопротезирование является единственным радикальным методом лечения деформирующего ОА. Все остальные методики позволяют лишь замедлить развитие болезни и улучшить самочувствие пациента.
Клеточная и тканевая инженерия
Данные направления медицины занимаются изучением проблем регенерации хрящевой ткани. Суставные хрящи пробуют восстановить с помощью клеточно- и тканеинженерных конструкций (КИК и ТИК). Эти два подхода имеют одну и ту же цель – заместить разрушенные фрагменты хрящей нормальной, полноценной тканью.

Не путайте инженерию с трансплантацией. Это два совершенно разные понятия. Запомните, что аутотрансплантация собственных тканей или жидкостей не является методом клеточной или тканевой инженерии. Об этих методиках речь идет лишь в случае применения искусственно синтезированных или культивируемых биоматериалов.


Биомедицинские клеточные продукты для регенерации хрящевой ткани
В наше время в клиническую практику постепенно внедряются биомедицинские клеточные продукты, содержащие аутологичные (то есть принадлежащие самому человеку) хондроциты. Одни лекарства представляют собой чистый субстрат этих клеток, другие содержат еще и биодеградируемый носитель (матрикс, скаффолд).
Факт! Ученые считают, что для культивирования лучше всего использовать хрящевые клетки носовой перегородки. Они обладают достаточно высоким потенциалом для дифференциации, а получить их совсем несложно.
Таблица 1. Средства для восстановления хрящевой ткани.
Помимо перечисленных в таблице существует множество других продуктов клеточной инженерии (Chondrogen, MACI, ChondroCelect и т.д.), которые теоретически можно использовать для восстановления поврежденных хрящей. К сожалению, все они пока что проходят разные фазы клинических испытаний. Это значит, что в практической медицине они начнут применяться как минимум через несколько лет.
Создание искусственных хрящей
Не так давно ученые были уверены, что суставной хрящ окажется одной из первых искусственных тканей. Однако в процессе его создания разработчики столкнулись с целым рядом трудностей. Как выяснилось, скопировать структуру и биомеханические свойства хрящевой ткани крайне трудно, практически невозможно.
В наши дни все еще продолжается работа над созданием искусственных хрящей, которые в точности повторяли бы структуру естественных. Пока что данное направление инженерии считается наиболее перспективным. Вполне возможно, что создание качественных ТИК вскоре станет настоящим прорывом в лечении деформирующего артроза.
Методы клеточной и тканевой инженерии пока что находятся на стадиях разработки и внедрения в клиническую практику. Они выглядят довольно перспективно, но пока что не могут полностью заменить эндопротезирование. Однако существует высокая вероятность того, что уже через несколько десятилетий от артроза можно будет избавиться с помощью нескольких уколов.
Методы аутотрансплантации
Аутологичная трансплантация – это использование собственных тканей и жидкостей пациента для введения в суставную полость. В наши дни с этой целью применяют хондроциты, клетки-предшественницы из надкостницы и надхрящницы, обогащенную тромбоцитами плазму (ОТП), мультипотентные мезенхимальные стволовые клетки (ММСК).

На начальных стадиях болезнь не диагностируется, так как не бывает жалоб, все проходит бессимптомно.
Восстановление хрящевых тканей эффективно только на начальных стадиях остеоартроза, когда в патологический процесс еще не вовлечены кости. К сожалению, методики инженерии и аутотрансплантации пока что не позволяют устранить дефекты костной ткани. Человеку с III-IV стадией ОА может помочь только эндопротезирование.
Обогащенная тромбоцитами плазма
Известно, что тромбоциты содержат факторы роста и вещества, которые являются потенциальными хондропротекторными агентами. Следовательно, ОТП можно с успехом использовать для стимуляции регенеративных процессов в суставных хрящах. Отметим, что хорошего эффекта от лечения можно добиться лишь с помощью плазмы, содержащей не менее 1000 000 тромбоцитов в 1 мкл.

ОТП добывают путем двухступенчатого центрифугирования венозной крови. Полученный материал вводят в количестве 5 мл трижды с интервалом в 2-3 дня. Будучи абсолютно безопасной, данная методика позволяет улучшить функциональное состояние сустава и повысить качество жизни пациента. Отметим, что применение обогащенной тромбоцитами плазмы более эффективно у молодых пациентов с незначительными дегенеративными изменениями суставов.
Стромально-васкулярная фракция жировой ткани
В наше время в регенеративной медицине используются ММСК, полученные из костного мозга и жировой ткани. Причем применение последних является более оправданным ввиду их несложного получения, высокого пролиферативного потенциала и низкого коэффициента старения. Отметим, что из эквивалентного количества жировой ткани можно получить в 1000 раз больше мультипотентных мезенхимальных стволовых клеток.

Стромаваскулярной фракцией (СВФ) называют совокупность всех ядерсодержащих клеток (в том числе и ММСК), которые можно добыть из подкожного жира путем ферментативного расщепления. Данная субстанция обладает выраженным регенерирующим, противовоспалительным, антисептическим и иммуномодулирующим действием. По мнению многих ученых, СВФ жировой ткани обладает массой преимуществ по сравнению с методами клеточной инженерии и культивированием ММСК.
Факт! Для приготовления СВФ не нужно культивирование, которое может осложниться микробной контаминацией, генетической трансформацией или спонтанной дифференцировкой. Это делает стромально-васкулярную фракцию более привлекательным продуктом для применения в клинической практике.
Синовиальное протезирование
Как известно, при остеоартрозе нарушается качественный состав, вязкость и упругость внутрисуставной жидкости, что ведет к постепенному разрушению хрящей. Исправить эту ситуацию можно путем внутрисуставного введения протеза синовиальной жидкости – очищенного гиалуроната натрия с хорошими вязкоупругими свойствами.

Доказано, что инъекции гиалуроновой кислоты позволяют замедлить развитие артроза и восстановить функции сустава. Отметим, что метод практически бесполезен на ІІІ и ІV стадиях ОА, сопровождающихся выраженными деструктивными изменениями костей. С его помощью можно лишь временно облегчить боль и улучшить самочувствие. К сожалению, вскоре неприятные симптомы возвращаются вновь.
Не так давно ученые выяснили, что эффективность синовиального протезирования можно повысить с помощью простых и доступных методов. К примеру, периартикулярные инъекции ферментных препаратов (Лидаза, Ронидаза, Лонгидаза) и мануальная терапия помогают добиться более удовлетворительных результатов, чем монотерапия препаратами гиалуроновой кислоты. Отметим, что выполнение инъекций под УЗ-контролем делает процедуры менее опасными.


Таблица 2. Наиболее популярные протезы синовиальной жидкости.
| Препарат | Производитель | Описание |
| Ферматрон | Хайэлтек, Великобритания | Выпускается в специальных шприцах для внутрисуставных инъекций. Лекарство вводится в синовиальную полость 1 раз в 7 дней. Чтобы добиться заментых результатов, требуется 2-3 укола. Стоимость разовой дозы Ферматрона – 4100 рублей. |
| Остенил | Хемедика, Германия | Препарат выпускается в готовых для использования шприцах. Вводится раз в 14 дней. Курс лечения может состоять из 2-3 инъекций. Одна упаковка лекарства стоит 3650 рублей. |
| Синокром | Крома Фарма, Германия | Вводится в синовиальную полость в асептических условиях. Курс лечения Синокромом обычно состоит из 4-5 инъекций, выполненных с интервалом в 1 неделю. Цена одного шприца – 4200 рублей. |
| Суплазин | Бионик Тео, Ирландия | Выпускается в разных дозировках. Вводится 1 раз в неделю. Продолжительность лечения зависит от тяжести заболевания. Как правило, пациента лечат 3-6 недель. Ориентировочная стоимость 1 инъекции – 3450 рублей. |
| Синвиск | Джензайм Европа Б.В,США | Протез выпускается в упаковках по 3 и 6 шт. Вводится с интервалом в 1 неделю. Чтобы получить хороший эффект, нужно сделать как минимум три инъекции. Одна упаковка Синвиска стоит 24 700 рублей. |
В 2007 году американские ученые выяснили, что некоторые группы хондропротекторов влияют на хондроциты и их предшественники – мезенхимальные стволовые клетки. Однако многие врачи и ученые ставят под сомнение эффективность хондропротекторов в лечении остеоартроза. Наиболее распространенным является мнение, что эти препараты замедляют разрушение хрящей, но НЕ восстанавливают имеющиеся дефекты.
Болезни суставов в большинстве случаев носят хронический характер и постоянно причиняют больному страдания. Стандартная схема консервативного лечения подразумевает пожизненный прием хондропротекторов (хондроитина, глюкозамина) и нестероидных .
Болезни суставов в большинстве случаев носят хронический характер и постоянно причиняют больному страдания. Стандартная схема консервативного лечения подразумевает пожизненный прием хондропротекторов (хондроитина, глюкозамина) и нестероидных противовоспалительных препаратов. При их низкой эффективности назначаются глюкокортикоидные гормоны. Но препараты не могут остановить дегенерацию суставного хряща, а лишь уменьшают выраженность симптомов.

Но медицина развивается. Появляются новые методы лечения, которые становятся альтернативой эндопротезированию. Они уже широко применяются в развитых странах, таких как США, Германия, Швейцария. Сегодня благодаря медицинскому туризму любой человек, имеющий желание и финансовые возможности, может воспользоваться услугами врачей ведущих клиник Европы для восстановления хрящевой ткани суставов.
Аутологичный матрикс-индуцированный хондрогенез
Методика предполагает использование собственных мезенхимальных стволовых клеток для восстановления хрящевой ткани. Результаты от лечения развиваются постепенно, достигая максимума через 1-2 года.
Внутри костей содержатся стволовые клетки. В зависимости от условий пребывания, они могут превращаться в любые другие клетки организма. Задача лечения: обеспечение проникновения стволовых клеток из кости в сустав.

Суть метода лечения:
1. Проводят операцию, в ходе которой создаются дефекты костной ткани.
2. Через эти дефекты в сустав проникают мезенхимальные стволовые клетки.
3. Дефекты закрываются матрицей. Они удерживают кровяные сгустки и костный мозг. Матрица обычно представляет собой мембрану из коллагена.
Постепенно вышедшие стволовые клетки дифференцируюся до хондроцитов. Эффект можно усилить путем применения обогащенной тромбоцитами плазмы. Также возможно более глубокое проникновение в кость при помощи спицы Киршнера, что в итоге дает больший выход мезенхимальных клеток и улучшение терапевтических результатов.
Имплантация аутологичных хондроцитов
Пересадка собственных хрящевых клеток используется при дефектах хрящевой ткани более 2,5 квадратных сантиметров. Современные варианты этого метода лечения суставной патологии предполагают использование коллагеновой мембраны для фиксации хондроцитов (в операциях первого поколения использовалась надкостница).

Суть метода:
1. У пациента берут фрагмент хряща.
2. Культивируют для увеличения количества хондроцитов до 15-20 млн.
3. Дефект закрывается коллагеновой мембраной.
4. Под мембрану вводят хондроциты через отверстие, которое затем герметизируется.
Существуют усовершенствованные варианты имплантации хондроцитов. Они предполагают использование матрицы для фиксации клеток.
Имплантация матриксиндуцированных аутологичных хондроцитов
Суть метода лечения:
1. Врач берет фрагмент ненагружаемого суставного хряща для культивации. В процессе артроскопического хирургического вмешательства выполняется диагностика: определяется характер хрящевого дефекта и сопутствующие повреждения.
2. Биоптат хряща ферментируется. Из него выделяются хондроциты – клетки хрящевой ткани. Затем их культивируют в течение нескольких недель. Цель – получение 28,8 миллионов клеток.
3. Клетки наносятся на биорезорбируемый 3D матрикс. Затем в ходе второй операции он имплантируется в сустав, замещая собой хрящевой дефект. Такой подход обеспечивает восстановление гиалиновой хрящевой ткани.
Таким образом, из небольшого фрагмента хряща пациента выращивается большое количество клеток, которые восполняют дефицит суставной поверхности. Это позволяет добиться длительной ремиссии заболевания– от 5 до 10 лет. Лучшие результаты достигаются у молодых пациентов.

1. Нет реакции отторжения трансплантата,потому что для пересадки используются собственные клетки.
3. Матрица рассасывается самостоятельно в течение нескольких месяцев, а хондроциты (клетки хрящевой ткани) полностью заполняют дефект.
4. Ускоренный протокол реабилитации. Уже через 6 месяцев после лечения допускаются умеренные физические нагрузки – бег, езда на велосипеде. А через 12 месяцев разрешены контактные виды спорта и практически любые нагрузки высокой интенсивности.
Недостатки метода имплантации матриксиндуцированных аутологичных хондроцитов: более высокая стоимость и необходимость проведения двух операций. Но результаты лечения вполне оправдывают эти недостатки. На сегодняшний день это один из лучших способов восстановления хрящевой ткани поврежденного сустава.

Все поверхности суставов сверху покрыты хрящевой тканью. В зависимости от многих факторов, толщина хряща бывает от одного до семи миллиметров. Влияет на толщину хряща степень нагрузки, тип сустава. Скажем, в коленном суставе толщина хрящей гораздо больше, чем в локтевом суставе.
У молодых людей хрящевая поверхность упругая и гладкая. У лиц старшего возраста ткань хряща теряет упругость, становится желтоватого цвета. Старые хрящи твердые, скрипучие, неэластичные.
Как происходит питание хрящей
Питание хрящи суставов получают посредством синовиальной жидкости. Также в доставке необходимых элементов принимают участие сосуды субхондральной зоны. Если взглянуть на хрящ через микроскоп, то можно увидеть, что он состоит из хондроцитов — так называются клетки хрящей. А также матрикса.
Что такое матрикс?
Матриксом называется межклеточный каркас, который состоит из коллагеновых волокон. Главная задача хондроцитов — постоянно обновлять матрикс, который быстро изнашивается. Состав матрикса на 70 процентов из воды, и на 30 процентов из протеогликанов. Такая пропорция позволяет матриксу выдерживать очень большие нагрузки. Так что матрикс для суставов — самый незаменимый элемент.
Лекарственные средства
Существуют на рынке различные препараты, которые поддерживают функции матрикса. В данной статье я не буду рекомендовать какие-то конкретные названия. Все они в той или иной степени обновляют тканевую структуру.
Однако, на мой взгляд, первостепенное значение в деле сохранности суставов надо отдать правильному питанию. Именно в этом кроется секрет здоровых коленей и локтей. Да и остальных трущихся частей тела. Так что старайтесь не подсаживаться на лекарства, а попробуйте заняться собой. Поменяйте свой рацион, откажитесь от вредной пищи.
Ко мне регулярно теперь заходят люди по запросу матрикс для суставов. Хочу внести ясность по этому пункту. Кто-то предприимчивый решил сделать деньги на том, что люди будут покупать эту поделку в надежде на исцеление. Но увы, это просто игра на эмоциях и надежде.
Да и стоит препарат, судя по комментариям больше тысячи рублей. Откуда такие деньги у, скажем, пенсионеров? Поэтому и не стоит тратить деньги на неизвестно что. Лучше следить за диетой и стараться вести здоровый образ жизни. Вот главный постулат. Тогда и суставы обновятся и скажут вам спасибо.
Кстати, вот и фото этого чудо-препарата:

Что сказать? Ну не доверяю я таблеткам… Считаю, что здоровье суставов не купишь за деньги. Можно только своими собственными усилиями изменить ситуацию из безнадежной в сторону улучшения. И подход должен быть комплексный — а именно пересмотр питания, чистки организма и ежедневная посильная физическая активность.
Это так сказать три кита здоровых суставов. А все эти БАДы и прочие разводки не советую даже пробовать. На вас делаю деньги.
Рассуждения про матрикс для суставов: 14 комментариев
Наша жизнь целиком и полностью зависит от подвижности суставов. В каком они состоянии, так человек и активен. У вас много информации по суставам. Спасибо!
А я думала, что матрикс — это какое-то лекарство для суставов.
Много всего нам еще предстоит о себе узнать. Раньше все было подвижно, а к старости одни сплошные немощи одолевают. Уже страшно подумать, что там впереди.
Я купил этой осенью кальциевый комплекс Витамакс. Он очень хорошо насыщает костный матрикс. Помимо этого препарат еще и помогает белковому матриксу. Есть и такой. Именно на него происходит наслоение кальция. Обратите внимание, если просто забивать организм кальцием, то это лишь будет способствовать увеличению хрупкости костей. Они будут тверже, да. Но и хрупче станут. Это как сосульки. С виду твердые, а упадет и рассыпется на много осколков.
Я купил препарат, он так и называется матрикс для суставов — такое желеобразное типа геля. Сейчас уже, спустя месяц применения наблюдаю значительные улучшения.
А кто производитель этого препарата?
Не скажу, что матрикс очень помогает. да и цена у него явно завышенная. Стоит он почти 900 рублей, это очень большие деньги. У меня отец перепробовал все эти препараты. А в итоге помогла реально только диета и гимнастика для суставов.
Да я готов любые деньги заплатить, лишь бы помогало. Какие могут быть экономии, когда уже и ходишь с трудом? Дело же не в деньгах ,а в том насколько этот матрикс помогает.
Матрикс как лекарство для суставов мне просто не по карману — цена у него около 1300 рублей! И где мне, преподавателю найти такие средства?
Захаживаю время от времени в нашу поселковую аптеку. Там про такое средство не слышали. Смотрели на меня с выпученными глазами.
Минздрав России допустил к продаже БАД Матрикс от компании Смирнов и Партнеры. Препарат проверили в институте академии наук и дали добро на продажи. Это для тех, кто все-таки хочет попробовать.
Посмотрела в интернете состав: глюкозамин 300мг, хондроитин 100мг в одной капсуле — это тот же состав, что и БАД Хонда, который Вы принимали и описывали здесь, только без травок и глюкозамина больше. Почему тогда негативное отношение к Матрикс?
Я присматриваюсь пока, что бы попробовать и врача поспрашивать. Еще о Тяньши слышала хороший отзыв от знакомой, а в интернете страшно ругают все. Я на распутье.
Оксана, все дело в том, что он у нас не продается. Поэтому мой опыт только по Хонде, а о Матриксе могу только рассуждать. Но это только мое мнение, опыта не было. Вот как попробую, так непременно опишу свои впечатления. А пока только рассуждения.
Примерно раз в месяц обгладываю вареные куринные лапки. вот и все лечение.

МАТРИКС-АРТРО ПРОФИ
ЛАЗЕРНЫЙ КОМПЛЕКС МАТРИКС-АРТРО ПРОФИ
СОСТАВ КОМПЛЕКСА :
60 680 руб.
тел. +7 495 799-17-14,
ПОКАЗАНИЯ К ПРИМЕНЕНИЮ АППАРАТОВ ЛАЗЕРНОЙ ТЕРАПИИ МАТРИКС В АРТРОЛОГИИ:
- Ревматоидные артриты
- Артрозы
- Эпикондилиты
- Плечелопаточный периартрит
- Деформирующий остеоартроз
- Бурситы
- Тендиниты
- Миозиты
- Пяточная шпора
- Фибромиалгия
Лазерное излучение при заболеваниях суставов рекомендуется применять в подостром периоде течения патологического процесса. Лазерная терапия проводится курсами 2 раза в год, в комплексе терапевтических мероприятий. Курс лечения должен начинаться за 2 недели до предполагаемого обострения.
Основное условие успешной терапии – разгрузка и покой пораженного сустава (использование палочки при ходьбе, ограничение подвижности, иммобилизация).
Курс состоит из 10–12 ежедневных процедур. Повторный курс можно провести через 3 недели. Общее время сеанса не должно превышать 10 мин. Не нужно стремиться лечить все пораженные суставы. Целесообразно выбрать 2–3 сустава, наиболее беспокоящих больного в данный момент.
При заболевании мелких суставов кистей и стоп их облучают с тыльной стороны в точке наибольшей болезненности. Локтевые, лучезапястные, голеностопные суставы облучают со сгибательной и разгибательной сторон каждый. На плечевые, коленные суставы воздействие производится с трех сторон. Тазобедренные суставы облучают через зону проекции пупартовой связки, большого вертела и седалищного бугра. Облучение полями осуществляют по проекции суставной щели.
ОПИСАНИЕ ЛАЗЕРНОГО КОМПЛЕКСА МАТРИКС-АРТРО ПРОФИ:
Действующий фактор: импульсное инфракрасное лазерное излучение с длиной волны 890 нм и регулируемой мощностью от 0 до 20 Вт.
Излучающая головка работает в импульсном режиме, обеспечивает глубокое проникновение инфракрасного излучения для терапевтического воздействия.
Действующий фактор: импульсное инфракрасное лазерное излучение с длиной волны 890 нм и регулируемой мощностью от 0 до 80 Вт
Магнитная насадка с напряженностью магнитного поля 100 мТл. Используется с матричной излучающей головкой МЛ-904-80.
Магнитная насадка с напряженностью магнитного поля 50 мТл. Используется с головками типа ЛО и КЛО.
Аппараты серии МАТРИКС, все излучающие головки и насадки к ним имеют Регистрационное удостоверение и Декларацию соответствия МЗ и СР РФ.
Гарантия на аппараты МАТРИКС – 5 лет.
МАТРИКС-АРТРО СТАНДАРТ
ЛАЗЕРНЫЙ КОМПЛЕКС МАТРИКС-АРТРО СТАНДАРТ
СОСТАВ КОМПЛЕКСА :
26 700 руб.
тел. +7 495 799-17-14,
ПОКАЗАНИЯ К ПРИМЕНЕНИЮ АППАРАТОВ ЛАЗЕРНОЙ ТЕРАПИИ МАТРИКС В АРТРОЛОГИИ:
- Ревматоидные артриты
- Артрозы
- Эпикондилиты
- Плечелопаточный периартрит
- Деформирующий остеоартроз
- Бурситы
- Тендиниты
- Миозиты
- Пяточная шпора
- Фибромиалгия
Лазерное излучение при заболеваниях суставов рекомендуется применять в подостром периоде течения патологического процесса. Лазерная терапия проводится курсами 2 раза в год, в комплексе терапевтических мероприятий. Курс лечения должен начинаться за 2 недели до предполагаемого обострения.
Основное условие успешной терапии – разгрузка и покой пораженного сустава (использование палочки при ходьбе, ограничение подвижности, иммобилизация).
Курс состоит из 10–12 ежедневных процедур. Повторный курс можно провести через 3 недели. Общее время сеанса не должно превышать 10 мин. Не нужно стремиться лечить все пораженные суставы. Целесообразно выбрать 2–3 сустава, наиболее беспокоящих больного в данный момент.
При заболевании мелких суставов кистей и стоп их облучают с тыльной стороны в точке наибольшей болезненности. Локтевые, лучезапястные, голеностопные суставы облучают со сгибательной и разгибательной сторон каждый. На плечевые, коленные суставы воздействие производится с трех сторон. Тазобедренные суставы облучают через зону проекции пупартовой связки, большого вертела и седалищного бугра. Облучение полями осуществляют по проекции суставной щели.
ТЕХНИЧЕСКИЕ ХАРАКТЕРИСТИКИ:
Действующий фактор: импульсное инфракрасное лазерное излучение с длиной волны 890 нм и регулируемой мощностью от 0 до 20 Вт.
Магнитная насадка с напряженностью магнитного поля 50 мТл. Используется с головками типа ЛО и КЛО.
Аппараты серии МАТРИКС, все излучающие головки и насадки к ним имеют Регистрационное удостоверение и Декларацию соответствия МЗ и СР РФ.
Лечение артроза коленного и тазобедренного сустава в домашних условиях
Что делать, если начали болеть суставы? Считается, что процесс разрушения суставов – артроз – необратим, дальше будет только хуже, и все закончится операцией по замене сустава. Но есть способы лечения суставов в домашних условиях, и если делать упражнения для суставов ежедневно, они не только перестанут болеть, но и смогут восстановиться.

Артрозы — это невоспалительные изменения в суставах (в отличие от артритов – воспалений суставов). Причина их развития в том, что питательные вещества не поступают в суставные хрящи. Последние атрофируются (худеют и умирают), а кости под этими хрящами компенсаторно разрастаются, и нарушается циркуляция внутрисуставной жидкости. Как же развиваются артрозы?
Питание хрящевой ткани
Любой ткани, любому органу в организме человека нужны определенные условия, чтобы нормально существовать и работать. Такими условиями являются кровоснабжение, венозный и лимфатический отток и иннервация. С кровью клетки получают кислород, глюкозу и необходимые для их строительства вещества. Венозный и лимфатический оттоки являются, по сути, канализацией, которая уносит все продукты жизнедеятельности клеток.
А иннервация — это система управления, которая следит за тем, чтобы каждая клетка работала не сама по себе, как захочет, а вместе с остальными. Как в оркестре каждый инструмент играет свою партию под руководством дирижера, так и клетками управляет иннервация.
В нашем теле есть два очага мягких тканей, которые находятся в зоне высокого давления, — это межпозвонковые диски и суставные хрящи. Им, как и всем остальным, нужен хороший приток крови. Но своих собственных сосудов в них нет - если бы они были, их бы просто раздавило!
Как же питаются межпозвонковые диски и суставные хрящи, раз им, как и остальным, нужна кровь? Как губка, впитывая кровь из соседних тканей. Если вы губку сожмете, она отдаст то, что в ней есть, если отпустите, то она начнет всасывать в себя жидкость. Именно так питается хрящевая ткань. И для этого обязательно нужно, чтобы кости в суставах двигались — то сжимали их, то растягивали. Только тогда они будут получать необходимое питание.
Причины артрозов
Но суставные поверхности не представляют собой идеально ровные цилиндры. На них есть выпуклости и впадины. Соответственно, чтобы хрящ равномерно то сжимался, то растягивался по всей суставной поверхности, просто необходимо, чтобы впадинки одной кости приходились на выпуклости противоположной.
Если же кости в суставе встают не так, как должны стоять, и нарушается конгруэнтность суставных поверхностей, то хрящи перестают питаться, ибо где-то нет необходимого сдавления-растяжения, а где-то они просто механически раздавливаются из-за избытка напряжения.
Вот это со временем и приводит к развитию артроза! Это и есть атрофия суставного хряща. Именно таким образом развиваются все артрозы! Доказательство: при артрозах никогда не начинают болеть два одноименных сустава сразу. Процесс всегда начинается с одной стороны, и только через какое-то время добавляется проблема с другой.
Потому что мы все либо правши, либо левши, и тонус мышц в теле всегда неравномерный. Правши больше нагружают правую сторону, левши — левую. Соответственно, и мышечный дисбаланс, из-за которого кости встают в неправильное положение друг к другу, начинается с одной стороны раньше, а с другой — позже.
Как восстановить правильное положение костей друг относительно друга? Поскольку кости двигаются не сами по себе, а их положение и движение зависят от мышечного тонуса, то и убирается артроз путем восстановления мышечного баланса, расслаблением перенапряженной мышцы.
Можно ли восстановить суставы, если они "износились"
Здесь нужно разъяснить три вещи.
1. Боль при артрозе вызывает не сам артроз, а перенапряженная мышца. Поэтому боль в суставе уходит через несколько дней после ежедневного расслабления перенапряженной мышцы.
2. Ничто в нашем теле не "стирается" и не "изнашивается". Мы все знаем, что раньше, когда не было стиральных машинок, была такая женская профессия, как прачка. Прачки стирали руками целыми днями. Кто-нибудь видел или хотя бы слышал, чтобы прачки стирали руки если не по локоть, то хотя бы по запястье? Ткани в нашем теле живые, и все восстанавливаются! Раны заживают, а не остаются на всю жизнь! Поэтому говорить про то, что суставы "износились" или "стерлись" — полная глупость и абсолютное непонимание процессов, происходящих в живом организме!
3. Именно благодаря тому, что тело живое, возможен процесс восстановления тканей. Например, вам нужно поднять что-то тяжелое, а мышцы слабые, не могут. Вы начинаете их тренировать, усиливать. И через некоторое время они становятся больше, мощнее и уже могут поднять нужную вам тяжесть.
Поэтому даже самый запущенный артроз всегда при восстановлении полноценного кровоснабжения суставных хрящей начинает регрессировать, развиваться вспять. И думать, что артроз развивается один раз и навсегда — глупость. Его всегда можно убрать. Другое дело, что процессы изменения структуры тканей, особенно костной, идут достаточно медленно. Если боль можно убрать за несколько дней, для избавления от артроза необходимо несколько лет (в среднем два-три года).
И еще нужно повторить: очень важно понять, что все артрозы всегда вызваны мышечным перенапряжением. Поэтому для того чтобы убрать боль (а беспокоит человека не сам артроз, а именно боль) и артроз, необходимо расслабить перенапряженную мышцу. Далее расскажем, как это сделать в домашних условиях при самых распространенных артрозах – коленного и тазобедренного сустава.
Как вылечить гонартроз в домашних условиях
Гонартроз — это артроз коленного сустава, который развивается из-за постоянного напряжения квадрицепса (мышц передней поверхности бедра). Кости в коленном суставе смещаются, и в результате этого хрящ не получает питание и атрофируется. Тело, разумеется, пытается компенсировать нарушения за счет избыточного выделения суставной жидкости, воспалительных процессов, гипертрофии костной ткани и т.д. Это и есть артроз.
Чтобы вылечить артроз коленного сустава и снять боль, которая, собственно, и беспокоит человека, нет смысла применять какие-либо лекарства или мази, а тем более ставить искусственный сустав. От артроза вы сможете избавиться с помощью статической растяжки квадрицепса.
Для этого встаньте так, чтобы рядом была опора, за которую можно было бы ухватиться. Стоя на одной ноге, возьмите рукой больную ногу за стопу, согните ее в колене и разогните в тазобедренном суставе, растягивая переднюю поверхность бедра.
Оставайтесь в этом положении не менее двух минут. Затем отпустите ногу и потяните точно так же мышцы на другой ноге.

Бывает, в запущенных случаях человек не может взять больную ногу за стопу. В этих ситуациях поможет такой вариант упражнения: надо просто положить согнутую в колене ногу на что-то — стул, кресло и т.д. — и отвести корпус назад, разогнув ногу в тазобедренном суставе.

При запущенном гонартрозе бывает, что в суставной сумке развивается компенсаторный отек. Реализуется он через напряжение задних мышц бедра, преимущественно по внутренней поверхности. И убирать такое напряжение с помощью статического растяжения этих мышц можно за два-три дня, если делать растяжку несколько раз в день.
Подойдите к стулу, положите выпрямленную в колене ногу на стул, стопу противоположной ноги отведите в сторону так, чтобы таз тоже слегка развернулся в сторону от больной ноги. Наклонитесь к больной ноге и оставайтесь в таком положении не менее двух минут.
С помощью этих нехитрых упражнений вы сможете убрать боль в суставе быстро — всего за несколько дней. Артроз тоже начнет проходить, но на полное восстановление тканей костей потребуется намного больше времени — несколько лет. Растяжки нужно делать, исходя из принципов "чем больше, тем лучше" или "кашу маслом не испортишь". Количество повторений в день ограничивается только возможностями самого человека.
Лечение коксартроза с помощью упражнений
Коксартроз — это артроз тазобедренного сустава. Он образуется двумя суставными поверхностями — вертлужной впадиной (тазовые кости) и головкой бедренной кости.
Поскольку бедренная кость очень длинная (самая большая в человеческом теле), ее головка получает кровоснабжение не из общей артерии, которая снабжает кровью всю бедренную кость, а из дополнительной артерии из тазовой кости, которая в составе связки идет через тазобедренный сустав от тазовой кости до головки бедренной кости.
Эта уникальная особенность кровоснабжения приводит к тому, что питание суставного хряща бедренной кости нарушается не тогда, когда бедренная кость встает в неправильное положение относительно таза, а когда головка ее вдавливается в вертлужную впадину перенапряженными ягодичными мышцами, передавливая питающую ее артерию.
Вот так развивается коксартроз. И именно напряжение ягодичных мышц дает боль, которая беспокоит человека. С помощью упражнений боль убрать можно быстро, расслабив мышцы, а для избавления от артроза нужно намного больше времени.
Ягодичные мышцы очень мощные, большие. Они работают всегда, когда человек находится в вертикальном положении. И когда просто стоит, и когда идет, и при беге. Поэтому с течением времени в них накапливается остаточное напряжение (они "забиваются"). Соответственно, чтобы избавиться от боли, нужно расслабить ягодичные мышцы.
Принцип мышечного расслабления, как всегда, прост — нужно растянуть перенапряженные мышцы и подержать их в растянутом состоянии пять минут. Пять, потому что мышца очень мощная, большая, ей двухминутной растяжки недостаточно. И помним, что растягивать нужно мышцы обеих ног: хоть проблема начинается всегда с одной стороны, другая нога не в лучшем состоянии.
Приведу один из возможных вариантов растяжки ягодичных мышц.
Лягте на спину на пол в дверном проеме так, чтобы дверной косяк был примерно на уровне коленок. Закиньте одну ногу за противоположный косяк так, чтобы пятка свободно скользила по стене вниз. Расслабьтесь и контролируйте, чтобы таз не разворачивался вслед за поднятой ногой.
Хотя сам артроз тазобедренного сустава развивается из-за перенапряжения ягодичных мышц, практика показала, что они часто перенапрягаются компенсаторно из-за перенапряжения подвздошно-поясничных мышц. Поэтому нужно расслаблять и подвздошно-поясничные мышцы. Это можно делать разными путями, приведу два примера.
Лучшим вариантом растяжки является поперечный шпагат. Только обязательно переносите вес тела на руки. Если вес всего тела будет давить на ноги, мышцы не смогут расслабиться, так как будут удерживать этот вес, и напряжение останется. Поэтому нужно лечь животом на стол или стул, развести прямые ноги в стороны. И постоять в положении максимального разведения ног две минуты.
Для тех, кто не может сделать предыдущее упражнение, есть более простой способ расслабить подвздошно-поясничные мышцы. Но, конечно, он и менее эффективный.
Лежа на спине, согните ноги в коленях и сведите стопы вместе, а колени разведите в стороны. Для усиления эффективности упражнения можно положить руки на колени или бедра, помогая таким образом развести ноги сильнее. В таком положении тоже нужно оставаться не менее двух минут.
Читайте также:


